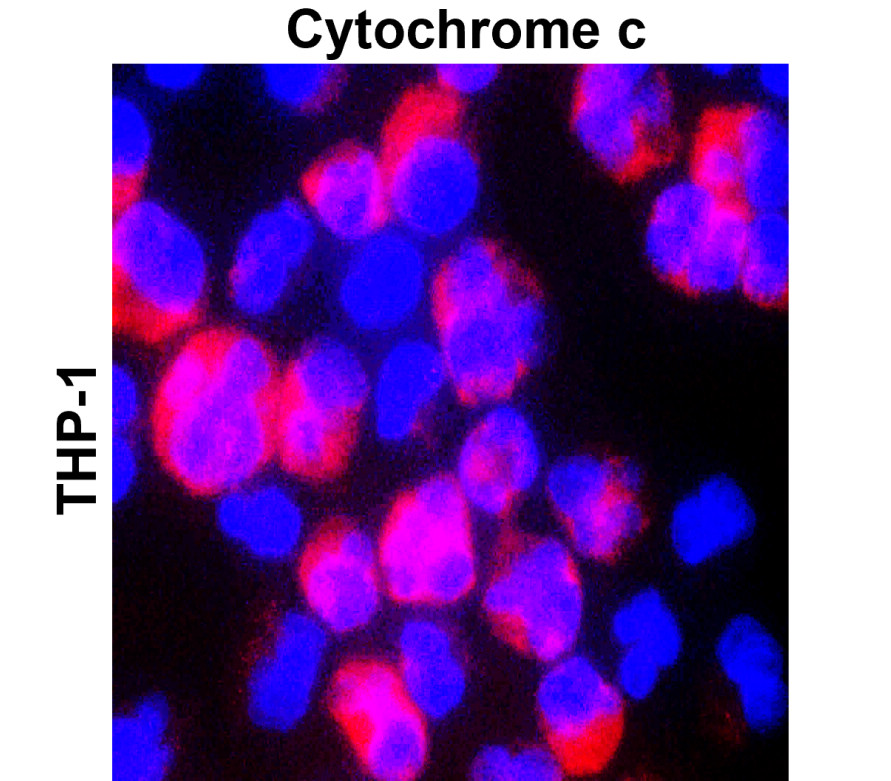

Product Includes
-
Application Dilution
Western Blot 1:1000-1:2000
Immunofluorescence 1:200-1:500
Immunohistochemistry (Paraffin) 1:200-1:400
Immunofluorescence 1:200-1:500
Immunohistochemistry (Paraffin) 1:200-1:400
Storage
Store at +4°C for short term storage. Long time storage is recommended at -20°C
100mM Tris Glycine, 20% Glycerol (pH7). 0.025% ProClin 300 was added as a preservative
100mM Tris Glycine, 20% Glycerol (pH7). 0.025% ProClin 300 was added as a preservative
Specificity / Sensitivity
Endogenous
Source / Immunogen
Synthetic peptide / encompassing a sequence within the center region
This gene encodes a small heme protein that functions as a central component of the electron transport chain in mitochondria. The encoded protein associates with the inner membrane of the mitochondrion where it accepts electrons from cytochrome b and transfers them to the cytochrome oxidase complex. This protein is also involved in initiation of apoptosis. Mutations in this gene are associated with autosomal dominant nonsyndromic thrombocytopenia. Numerous processed pseudogenes of this gene are found throughout the human genome.[provided by RefSeq, Jul 2010]